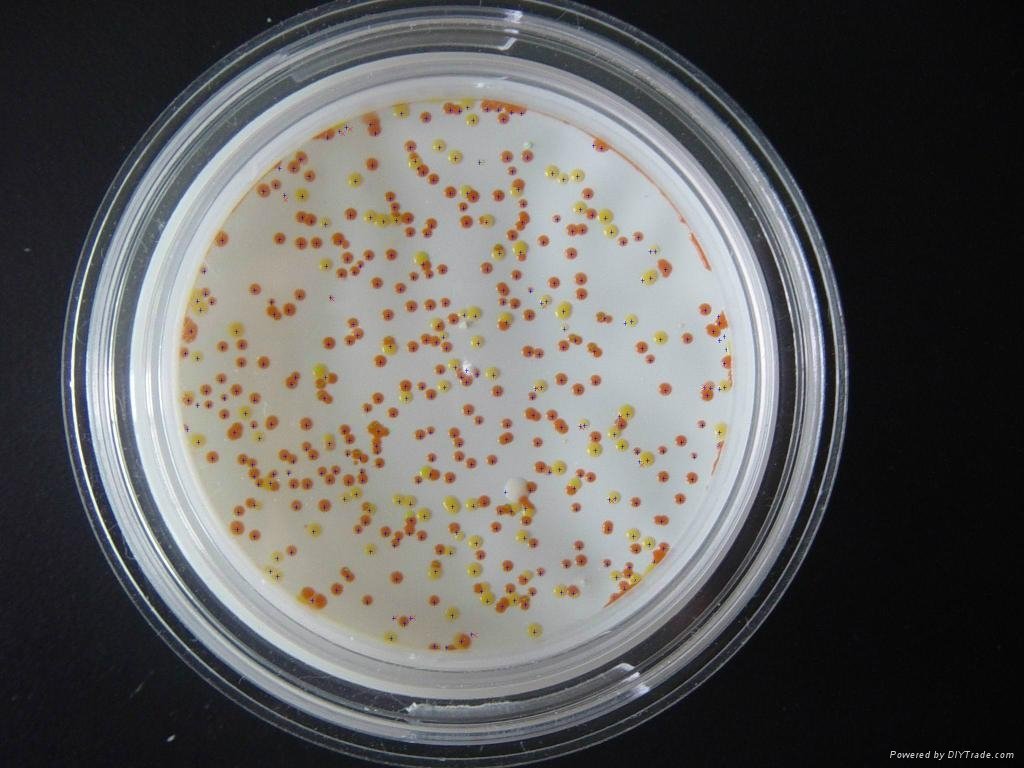

Profile: 3c31c0c8...
朝鲜队未能在乒乓球混双决赛中夺冠,回去后会不会受到金三胖的处罚? https://t.co/Mt1P45xCTp https://video.twimg.com/tweet_video/GTvUgiObAAAN6KU.mp4
全红婵2024年巴黎奥运会跳水比赛赛程安排(北京时间)
女子十米台双人(全红婵、陈芋汐参赛)
决赛:7月31日 17:00
女子十米台单人(全红婵、陈芋汐参赛)
预赛:8月5日 16:00
半决赛:8月5日 21:00
决赛:8月6日 21:00 https://t.co/Zwo6JaTm5L https://video.twimg.com/ext_tw_video/1818276757809893376/pu/vid/avc1/540x872/eLAWBYn4rDc_sKZZ.mp4?tag=12
巴黎奥运会体操男团决赛中国队以微弱分差憾负,获得银牌。
赛后,前中国体操队运动员,世界冠军、奥运冠军李小双在直播中表达对体操队教练组的意见。 https://t.co/JSxJQynImX https://video.twimg.com/ext_tw_video/1818268470976634880/pu/vid/avc1/720x1280/IiV2k93uke45xlyC.mp4?tag=12
浙江刘女士玩漂流突发意外,颠簸中颈椎6-7节完全断离,造成脊髓损伤全身瘫痪。 https://t.co/dGnbJxt3XM https://video.twimg.com/ext_tw_video/1818222307309211648/pu/vid/avc1/960x540/BWkYtkJ_2PIPJzhn.mp4?tag=12
肠易激综合症4个典型症状 https://t.co/YG1ImMuars 
金黄色葡萄球菌,隶属于葡萄球菌属,是革兰氏阳性球菌代表。以其独特的葡萄状排列形态而得名,广泛潜藏于自然界的各个角落,包括空气、人体表面如皮肤、鼻腔、咽喉乃至肠道内。
其强大的致病能力源自其能够产生多样化的毒素、酶及抗原蛋白,不仅能够引发皮肤软组织、血流、呼吸道等局部感染,更有可能导致全身性感染,严重威胁人类健康。
当食物受到金黄色葡萄球菌污染并发生变质时,消费者若不慎食用,极易诱发细菌性食物中毒,症状包括但不限于恶心、剧烈呕吐,甚至可能发展至休克等危及生命的严重状况。
上山误采断肠草煲汤中毒入院
近日,广东一对夫妻从山里采“五指毛桃”煲汤,吃后出现口吐白沫、意识不清、呼吸心跳骤停甚至多器官功能衰竭,被确认为误服断肠草(钩吻)中毒。 https://t.co/675ALRzerK https://video.twimg.com/ext_tw_video/1818154662174003200/pu/vid/avc1/720x1280/eXbidE8s27JQfFUr.mp4?tag=12
日本横滨京急百货售卖的“日本桥伊势定”鳗鱼便当,致1人死亡和147人呕吐或腹泻。横滨市判定“便当中有金黄色葡萄球菌”,症状属“食物中毒”,原因在详细调查中…… https://t.co/rDXiC6jUga https://video.twimg.com/ext_tw_video/1818124349528047616/pu/vid/avc1/1280x720/y5KNP3Vs8G79kb-R.mp4?tag=12
中国香港城市大学和美国奥古斯塔大学的研究人员,分析了6052名平均年龄50岁的参与者,收录了他们的入睡时间、起床时间、睡眠持续时间、入睡效率等,通过血液样本分析了其生物年龄。研究显示,与睡眠习惯稳定的人相比,入睡时间偏差较大、工作日和周末睡眠差异大的参与者生物年龄要老9个月。保持规律、稳定的睡眠习惯,有助于减缓机体衰老过程。提高睡眠的规律性,可能是延长健康寿命的一种新方法。https://t.co/4ArkIpq7n0
Temu供应商到拼多多广州总部维权 https://t.co/QvvhvYKPFv https://video.twimg.com/ext_tw_video/1817933292429254656/pu/vid/avc1/720x960/z4qXocf5sxsZYXis.mp4?tag=12 https://video.twimg.com/ext_tw_video/1817933292613799936/pu/vid/avc1/720x1280/3dKzj3xwpQo-lRLd.mp4?tag=12 https://video.twimg.com/ext_tw_video/1817933368434335744/pu/vid/avc1/720x1310/MXWUG74x78wnKoma.mp4?tag=12 https://video.twimg.com/ext_tw_video/1817933461526888448/pu/vid/avc1/720x1280/Nb7u7uJ75jVFXAJt.mp4?tag=12